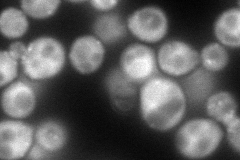
YCR009C
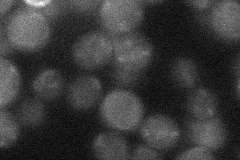
YCR009C
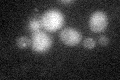
YCR009C

View description
Amphiphysin-like lipid raft protein; interacts with Rvs167p and regulates polarization of the actin cytoskeleton, endocytosis, cell polarity, cell fusion and viability following starvation or osmotic stress
Localization:
Intensity:
Fold change:
Significance:
-
C’ GFP library in SD

below threshold16.36 -
N' NOP1pr-GFP in SD
cytosol,punctate155.128 -
N' TEF2pr-mCherry in SD

missing0 -
N' NATIVEpr-GFP in SD
below threshold18.3104 -
N' TEF2pr-VC and Cyto-VN in SD

cytosol47.1804 -
C’ GFP library in SD+DTT
cytosol15.970.97No -
C’ GFP library in SD+H2O2

cytosol16.10.98No -
C’ GFP library in Starvation Media

cytosol21.651.32No -
C’ GFP library on the background of Pup2-DaMP

below threshold -
C’ GFP library on the background of CCT mutant

below threshold15.6460.955934No
